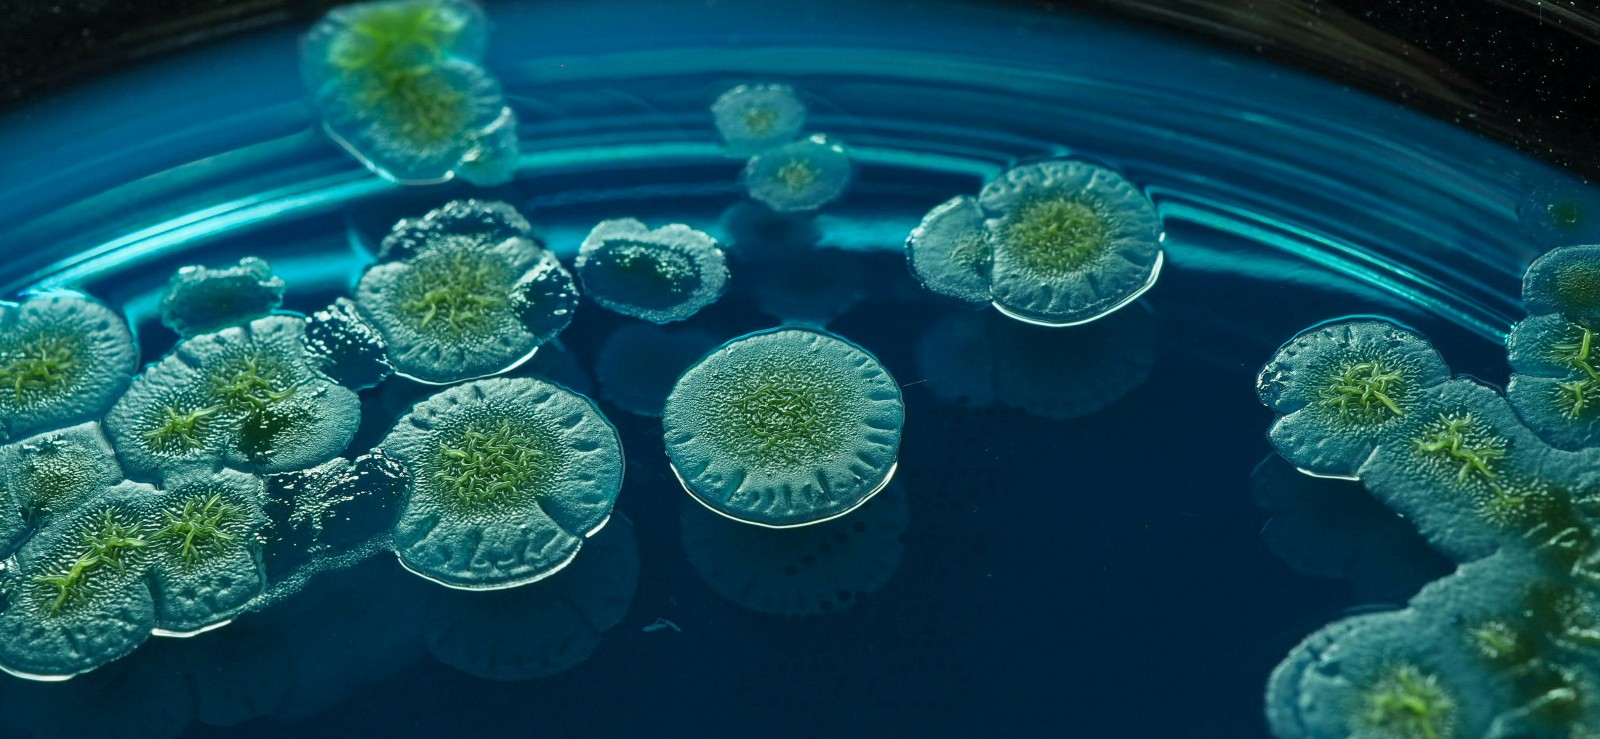
slider image

Leading the Way in Microbial
Innovations to Sustain Nature

Leading the Way in Microbial
Innovations to Sustain Nature